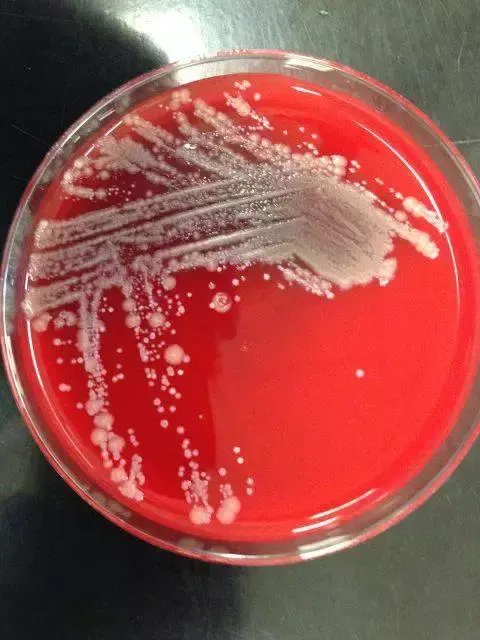
vocus｜新世代的創作平台
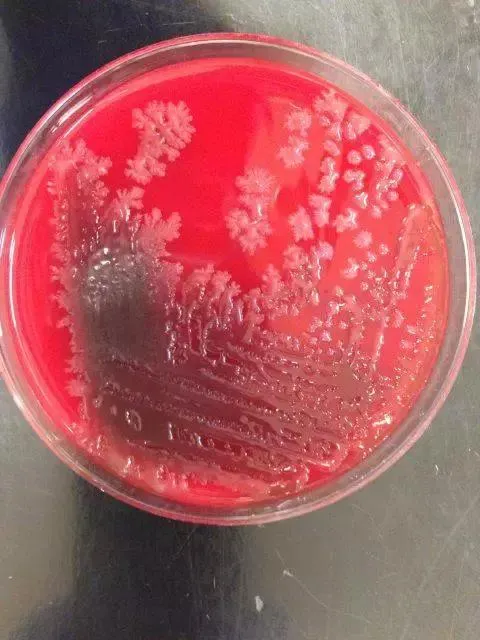
vocus｜新世代的創作平台

那天一名女主管,請教內衣👙怎麼清洗,我才想起:對吼!我當告知大家胸罩乾淨的重要性。
我在臨床,曾經遇過一位25歲的上班族,來我的門診,說她的胸部刺痛,問她哪裡痛?右邊痛!右手舉起也痛,我聽診和檢查完了一切正常,正在百思不解,因為她的疼痛表情非常真實,我忽然靈機一動問,妳自己檢查胸部有任何紅腫,癢痛嗎?她終於點頭,於是我檢查胸部,原來她右側乳房下緣出現紅腫,小痘痘,明顯的鋼缐壓痕的接觸性皮膚炎,天啊,她的右邊乳頭,比左邊更深深,且奇癢無比...我終於明白了,這是長期穿著又緊,又髒的胸罩造成的皮膚疾病。據她說,她為了省錢,她不常買胸罩,而且也不怎麼去淸洗,反正穿著在裡面,不太會有人發現的。妳的身邊有這樣的人嗎?胸部的污垢會沾到胸罩
我們胸部上的的「油脂」、「微生物」,夾雜著「污垢」全都會沾附在胸罩上,本來這些東西,跟我們接觸皮膚不會有太大的為害,但如果長時間沒有清洗胸罩、讓髒污垢在乳房周邊積越久,就可能引發一些皮膚疾病。
胸罩,會藏有多少細菌?
關於內衣細菌的研究, 英國發現,過1年的內衣,即使清洗乾淨,仍有83%的內衣平均還是殘存有《0.1g的糞便物質》(也就是1萬個細菌。而這些病菌,大家用肉眼都是看不到的。

美國皮膚兼病理專科醫生,Dr. Gretchen Frieling引述發現,可能聚集在胸罩中的常見微生物,包括:
金黃色葡萄球菌 ( Staphylococcus )
金黃色葡萄球菌實際上在人類皮膚上最常見。 我們的皮膚擁有自己的微生物菌落或生物種群,可以使它們保持健康和受到保護,而金黃色葡萄球菌,就是我們皮膚上細菌總數最多的細菌之一,也就會容易沾到胸罩了。
棒狀桿菌 ( Corynebacteria )
棒狀桿菌,其實不只生活在皮膚上,而且也是生活在,胃的微生物。 妳躺著吃東西,反胃,反酸掉了屑屑在胸口⋯⋯
眾所周知,這種細菌也許會引起痤瘡。如果妳發現,胸罩接觸部位,出現粉刺,則可能需要更換新的胸罩了。
酵母菌 ( Yeast )
皮膚出汗,製造出胸部潮濕環境,會有一些酵母菌茲生, 常造成汗斑、脂漏性皮膚炎
美國紐約皮膚科醫師Julia Tzu 提醒這些可能會造成胸部嚴重搔癢、紅色丘疹或膿皰性毛囊炎。皮屑芽孢菌 (pityrosporum ),是其特別常見的菌種之一。
為什麼胸罩易藏有細菌?
每次穿脫胸罩時,很多死皮膚屑都會掉落在胸罩上面。
美國皮膚科醫師,朱莉婭·祖祖(Julia Tzu)指出:“那些「死皮脫落」細胞和胸部「皮膚的油脂」,會積聚在緊身的織物上,胸罩就是其中之一。”
依據美國皮膚科醫學會稱,我們每天佔計胸部會掉損至少30,000 - 40,000 皮膚死細胞。
胸罩每天都穿,穿著者身上的油脂污染,這些油脂提供了皮膚上微生物生長所需的養料,隨後細菌,就會轉移到衣物纖維上。
滋養天堂三大條件:
【熱】的環境,【濕】的汗水,【油】脂分泌,提供了微生物的美食天堂。
胸部哪裡最髒?
美國托雷多大學( University of Tolendo ) 醫學中心微生物部的專家處檢查
Bra上的四個「高危」區域:左右罩杯的【鋼圈周圍】、以及靠近【左右腋窩】的部位。

1.罩杯鋼圈附近

2.右側腋窩附近部位
3.左側腋窩附近區域
什麼時候要換新的胸罩?
味道
胸罩會散發出臭味,而且臭味還可能會沾到其他衣服上。很多女生都會把自己胸罩,懸掛著,然後隔1-2天,再聞一聞,沒有味道,又重新穿上胸罩出門去了。
偷偷告訴大家,胸罩隔1-2天,又不是放「隔夜菜」,馬上會臭酸聞到的,更何況人類的鼻子👃又比狗差,所以妳會常常聞不到,再加上是自己身體的體味,妳的嗅覺習慣了,也分辨不出臭味了!
其實,胸罩直接貼著皮膚上,沾到的汗水最多。妳不洗胸罩,愈放愈久,就愈可能發臭。別以為胸罩穿在最裡面,不洗別人也不會發現,等到妳內衣發臭、其實到一定程度,妳身邊的人都會聞到的。只是大家不太會跟你說而已。
顏色
胸罩,會出現汙漬、甚至開始發黃,也只有妳自己看得到而已。就像我們穿白衣服,衣領䄂口,容易發黃的經驗。妳注意看看接觸皮膚的胸罩邊緣,很多細微的顏色改變。

反正污垢與汗水沉積,只要胸罩不洗,久了就會黃黃der,所以說,內衣記得要買深色?(那也許是欺騙自己眼睛👀?)
形狀
妳的胸罩,如果出現以下幾種情況,可能考慮換新的胸罩:
1.罩杯,往上移位
2.肩帶,往下滑位
3.胸部,有深厚壓痕 又紅又癢
4.背部,也已有勒痕 又紅又癢
5.罩杯,太鬆,空空的感覺
多久,洗一次胸罩?
大部分的專家都建議你在穿胸罩 : 同一件內衣,最多【2-3次後就應該洗一次】。
但是如果你「運動大量出汗」,或在「夏天季節」𥚃,那麼穿一次就應該洗一次,才乾淨。
有些文章,這樣形容:大熱天重新穿上沒洗的胸罩,會跟糞池一樣髒。
上面布滿了汗漬、灰塵、油脂、細菌、遮光劑、酵母菌、真菌以及數以萬計的微生物...還有一堆的死細胞的屑屑呢!
一周一次,這是最起碼的,一般來說,是要更勤便才行。
基本越貼身的衣物,越應該勤便換洗。
紐約大學醫學院病理專家Philip Tierno認為:
在穿【胸罩最多三次後,就應該洗一次】。然後如果你有大量出汗,那麼請穿一次,就應該洗一次,千萬不要太相信,妳的眼睛,妳的鼻子了...
胸罩,不是永遠保固產品
【胸罩,是消耗品】
胸罩的使用次數壽命,大概在100次左右,假設依照2-3天穿回同一件的內衣來說,胸罩,穿近一年就應該拋棄了。記得,每一個週年慶到了,就是記得可以購買新的胸罩了😛😝😜!
如何,淸洗胸罩?
淸洗胸罩,每日一個產品,或其網站都會有寫清洗注意事項,我這裡不細説了,大概大同小異簡單如下:
1.溫水,加入不含酒精成分的清洗劑;
2. 讓清洗劑,充分溶解於水中,不需要太多泡沫,否則將加重清洗難度;
3. 放入要洗的胸罩,如果是棉質胸罩最好為同色,合成材料則無需擔心
4. 將胸罩在肥皂水中浸泡10到15分鐘,以便清洗劑去處油污和污漬,特別髒的Bra可泡一小時
5. 輕輕揉搓胸罩,洗出污漬,通常此時水已變黑
6. 倒掉污水,用清水沖洗胸罩,直至水質不再變色;
7. 特別骯髒的胸罩,可以重複多次以上6個步驟;
8. 不可扭曲胸罩去水,可用兩塊干毛巾擠壓吸收水分;
9. 自然風乾胸罩:可以懸掛(注意應該掛在聯繫兩個罩杯的帶上,避免變形);也可以放在干毛巾上等待它們自然透風。
什麼時候,妳要看醫生?
反覆長痘痘的時候
容易流汗,長期有濕的環境。長時間的有病菌堆積,加上胸罩緊貼皮膚,摩擦之下,就可能在後背生出痤瘡、小心胸口和乳房邊緣下有丘疹。
不抓也癢、抓了也癢
胸罩可以保暖胸部,但也會是刺激皮膚的物品之一。
尤其是穿「太小,太緊,又不乾淨」的胸罩,易於造成皮膚摩擦,尤其當胸罩上一堆細菌髒東西,摩擦之後會讓皮膚又紅又癢。
癢的範圍,當然也包括奶頭囉。不管是奶頭或乳房,如果癢得要死,又不能常常抓,導致妳的生活交際出了問題,記得快點去看看醫生吧!
擦爛性濕疹 ( Intertrigo )

這一種濕疹,也有人叫《擦爛性濕疹》,好發於皺褶部位的皮膚。主要是皮膚皺襞處,胸罩和胸部皮膚表面密切接觸,局部濕熱散發不出,汗液滯留,導致浸漬濕濕,加上胸囗活動時,皮膚表面,會對緊貼著胸罩,不斷摩擦刺激,而引起了濕疹。
妳的胸罩,髒嗎?
問問妳自己,對待胸罩的生活行為,就知道妳的胸罩髒嗎 ?
1.不要天天,重複一直穿同一件內衣
2.記得最多重覆2-3次後,就應該洗一次
3.妳的鼻子👃、妳的眼睛👀 不能當作胸罩乾淨的評估工具。
4.不要一直買新的化妝品,忘了添購新的胸罩。
5.夏季,運動,易出汗者,可以天天換胸罩!
6.反覆出現又紅又癢,記得看醫生。
來源 :
https://kknews.cc/health/kpjr2p.html 沒洗的Bra跟糞池一樣髒,怎樣能洗凈
如果你已經看到最後 : 【免費支持我】
幫我按下方的【 拍手五下】,我有機會獲得內容創作的酬勞喔~
創作不易啊...























